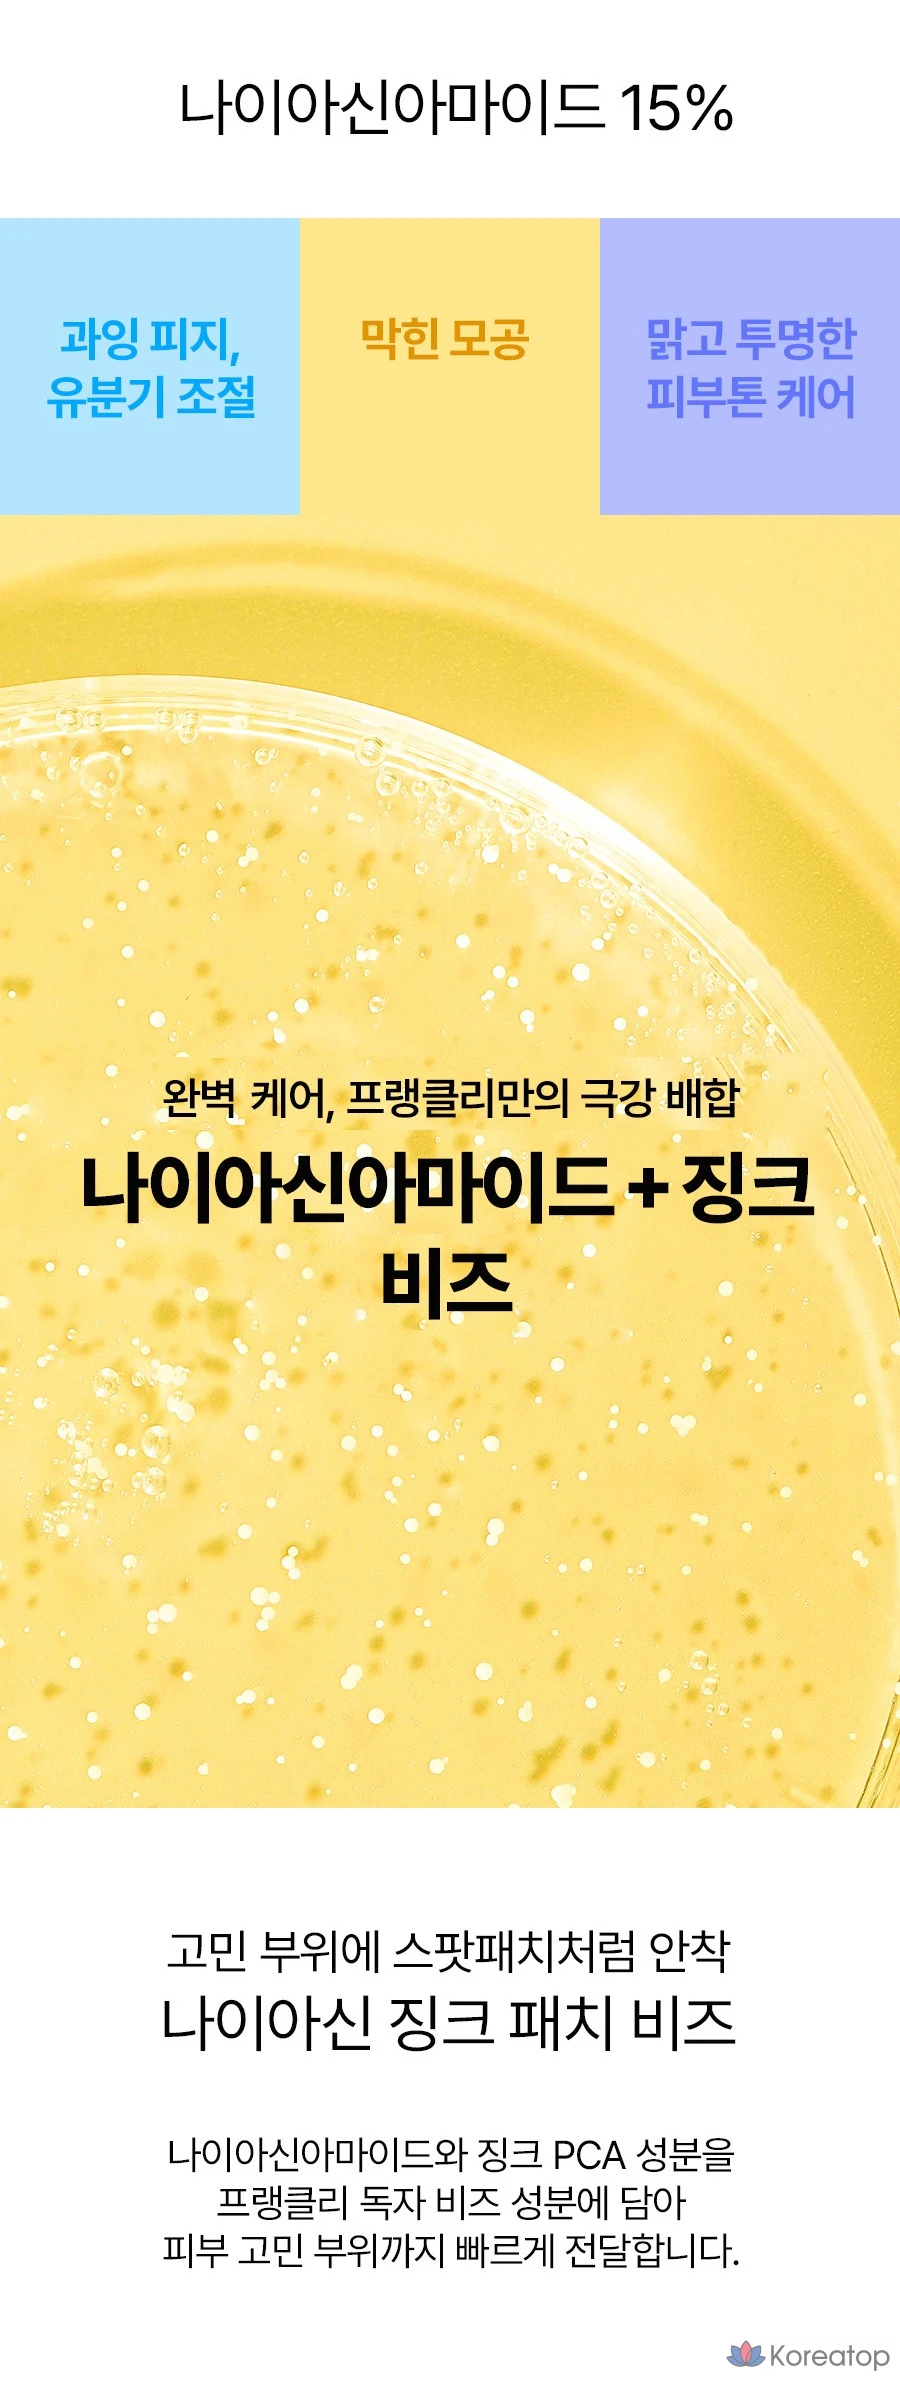

Сыворотка Frankly Niacinamide 15% Zinc B Serum, 30 мл, 1 шт.
Вам также может понравиться
сыворотка с гранулами
жирная, комбинированная, проблемная, с расширенными порами
ниацинамид (15%), цинк PCA, аденозин, гиалуроновая кислота
себорегуляция, сужение пор, осветление постакне, выравнивание тона, матирование
Мощный удар по несовершенствам! Эта концентрированная сыворотка с 15% ниацинамида — настоящий мастхэв для проблемной и жирной кожи. Уникальная текстура с инкапсулированными гранулами цинка (Zinc PCA) позволяет активным компонентам высвобождаться непосредственно при нанесении, работая максимально эффективно. Средство регулирует выработку себума, заметно сужает поры и матирует, предотвращая появление жирного блеска. Ниацинамид в высокой концентрации осветляет постакне и выравнивает общий тон кожи, возвращая ей здоровое сияние и отдохнувший вид.



















 Telegram
Telegram Вконтакте
Вконтакте Max
Max